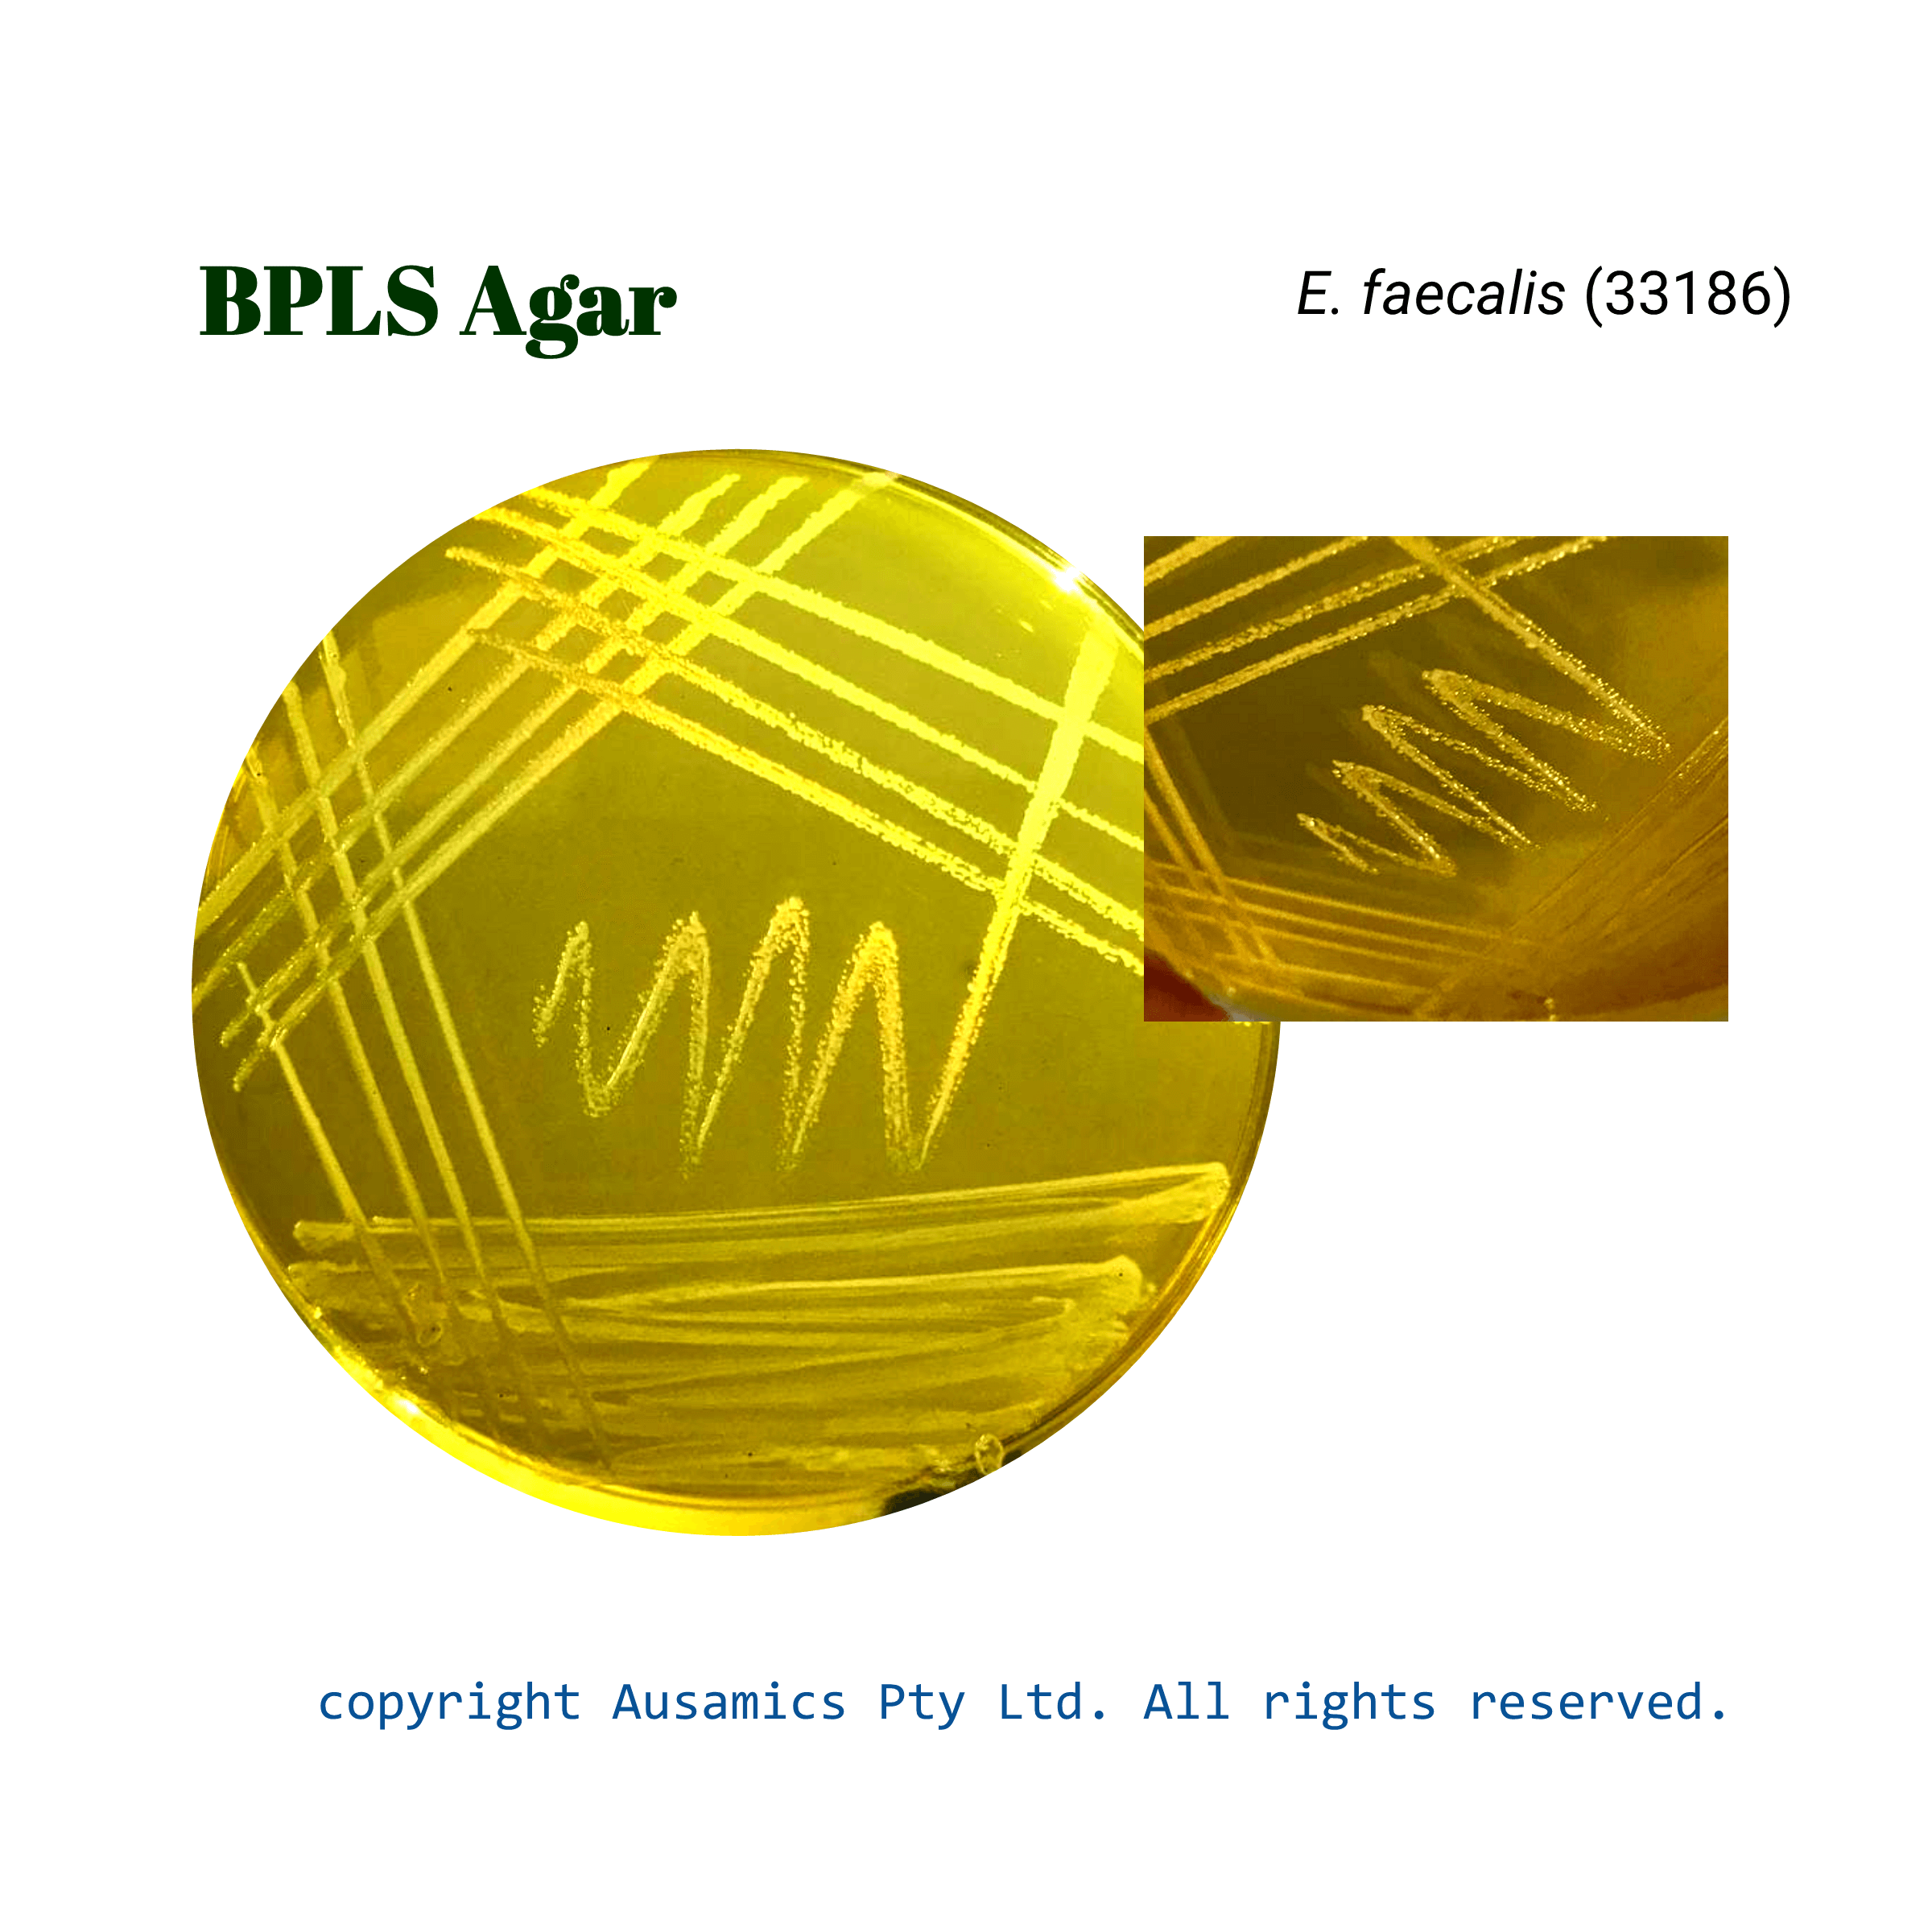

Brilliant-green Phenol-red Lactose Sucrose (BPLS) Agar
A selective culture medium for isolating Salmonella from pathological material, feces, urine, and foodstuffs, excluding S. typhosa and Shigella.
- Description
- Composition
- Quality Control
- Microbial Test Results
Brilliant Green Agar (BGA), sometimes referred to as BPLS agar, is a selective culture medium that is mostly used for Salmonella species isolation. Brilliant green, which inhibits the growth of most Gram-positive and many Gram-negative bacteria, is thought to be responsible for its selective properties. BPLS is frequently used in tandem with less inhibitory enrichment broths, such as selenite or tetrathionate, to improve recovery rates. Peptones supply vital nutrients, lactose and sucrose offer energy from carbohydrates, phenol red indicates pH, and sodium chloride preserves osmotic balance are the components of the medium.
Bacteria that do not ferment lactose or sucrose, like Salmonella, usually form pink to red colonies on BPLS agar. Conversely, because lactose and/or sucrose fermenters produce acid, their colonies appear yellow to green. Even though BPLS is quite selective, to ensure proper identification of suspected Salmonella isolates, confirmation testing must be carried out.
Storage
Keep the container at 15-30 °C and prepared medium at 2-8 °C.
| Composition | gr/L |
| Peptones | 10 |
| Meat Extract | 5 |
| Lactose | 10 |
| Sucrose | 10 |
| Disodium Hydrogen Phosphate | 2 |
| Sodium Chloride | 3 |
| Phenol Red | 0.08 |
| Brilliant Green | 0.0125 |
| Agar | 12 |
| Final pH at 25°C | 6.9 ± 0.2 |
| Dehydrated Appearance | Pink, free-flowing, homogeneous |
| Prepared Appearance | The prepared medium is clear and red. |
| Reaction of 5.2 % Solution at 25°C | pH 6.9 ± 0.2 |
| For 24 hours, incubate at 35 ± 2°. | |||
| Organism (ATCC) | Recovery | Colony color | Culture color |
| Escherichia coli (25922) | Good | Yellow | Yellow |
| Salmonella typhimurium (14028) | Good | Pink | Red |
| Staphylococcus aureus (25923) | Inhibited | – | – |
| Enterococcus faecalis (33186) | Inhibited | – | – |
| Bacillus subtilis (6633) | Inhibited | – | – |